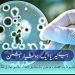
بیکٹیریا (Bacterium) ایک ہوشیار دشمن-bacteria

قدیم قوم (Ancient nation) کونسی؟
ویسے تو اسلامی اعتقادات کے مطابق دنیا کی ابتداء حضرت آدم ؑ سے ہو ئی مگر آثارِ قدیمہ یعنی باقیات اور نشانیاں جو کہ دنیا پر کبھی ہونے کی گواہی فراہم کرتی ہیں ان کے مطابق دنیا میں سب سے قدیم قوموں (Ancient nation) میں ہم برّصغیر کے لوگ اور ہسپانوی ہیں۔مؤرخین نے ہمارے اور ہسپانوی قوم کے سب سے پہلے وجود رکھنے والے لوگوں کے دورکو پالیولتھک کا نام دیا ہے۔جان لبوک نے دو یونانی اصطلاحوں ‘پلاؤس’ یعنی پرانا یا قدیم ا ور’ لتھوس ‘یعنی پتھر کو استعمال کر کے 1965 میں اس دور کا نام تجویز کیا۔یہ وہ دور تھا جسے عرفِ عام میں پتھروں کا زمانہ (old stone age era) یا سٹون ایج بھی کہا جاتا ہے۔
رہن سہن:
ابتدائی انسان کے نشانات انڈیا اور سپین کی سر زمین پہ ملتے ہیں۔اور جس مخصوص چیز سے اس دور کی پہچان ہوتی ہے وہ دراصل انکے پتھر سے بنے شکار اور حفاظتی آلات کے علاوہ پتھر کی غاروں میں انکی رہائش کے نمونے ہیں۔ہمارے یہ آباؤ اجداد 3 ملین سالوں قبل ہماری سر زمین پہ آباد تھے۔
نوع ِ انسانی اس دور میں چھوٹی چھوٹی ٹکریوں یا خاندانوں کی صورت میں رہتے تھے اور انکا گزر مچھلی کے شکار پودے اور جڑی بوٹیاں اکھٹی کرنے کے علاوہ جنگلی جانوروں کے شکار پر ہوتا تھا۔موسم اس دور میں بھی ٹھنڈے اور گرم ہوتے تھے۔البتہ تاریخ دانوں کے مطابق پولیو لتھک انسان گھنے جنگلات کی بجائے میدانی علاقوں اور دریاؤں کے کنارے آباد رہنے کو ترجیح دیتے تھے۔
اس دور کے لوگ غاروں کے علاوہ پتھروں (old stone age era) اور لکڑی کے گھر بنا کر بھی رہتے رہے لیکن یہاں تک ذہنی لحاظ سے پہنچنے میں انہیں کچھ وقت لگا۔ بعد میں آنے والی تاریخ میں یہی قدیم قوم (Ancient nation) دنیا کے باقی حصوں آسٹریلیا ،جاپان،امریکہ وغیرہ کے علاقوں میں پھیلے اور انسانی آبادی بڑھی۔
اوزاروں کا استعمال:
اگرچہ انکی پہچان پتھروں سے بنے اوزار ہیں لیکن ان اوزاروں کو بنانے میں لکڑی اور ہڈیوں کے استعمال کے شواہد بھی ملتے ہیں۔اسکے ساتھ ساتھ چمڑے اور سبزیوں کے ریشے بھی اوزاروں کی بنوائی میں استعمال کئے جاتے تھے۔افریقہ میں 50،000سال قبل تاریخ میں ہڈیوں سے بنے اوزاروں کے نمونےافریقہ کے بلمبوس نامی غار سے ملے ہیں جو کہ کافی اقسام پر مشتمل ہیں جن میں سب سے نمایا ں کھدائی ،شکار کرنےکے چاقو اور لٹکانے کے علاوہ جلدی کندہ کاری اور سوراخ کرنے کے اوزار ہیں۔
پتھروں کے زمانے (old stone age era) کے بعد نوعِ انسانی نےصرف اوزار بنانے اور طب میں ہی ترقی نہیں کی بلکہ معاشرتی اور سماجی لحاظ سے بھی اپنے آپ کو نکھارا ہے ۔آگ کا استعمال بھی سب سے پہلے ڈیڑھ سے 3ملین سالوں قبل پولیولتھک لوگوں نے ہی شروع کیا اور انہی نے پانی یعنی پہلے دریاؤں میں بڑے لکڑی کے ٹکروں کو سطح پر بہا کر سفر کا آغاز کیا۔اور بعد میں آنے والے وقتوں میں دنیا کے باقی حصوں تک انہی کے ذریعے پہنچے۔
آبادی میں کمی:
آبادی میں کمی کی بڑی وجہ عورتوں کا مردوں کے ساتھ بقاء کی جنگ میں برابر شامل ہونا اور پیدائشی عمل میں احتیاطی تدابیر کی کمی کے باعث پیدائش سے پہلے یا پیدائشی عمل کے دوران بچوںکا مر جانا تھا۔اسکے علاوہ موسموں کی سختیاں اور رہن سہن کے انداز بھی آبادی میں کمی کی وجہ تھے۔